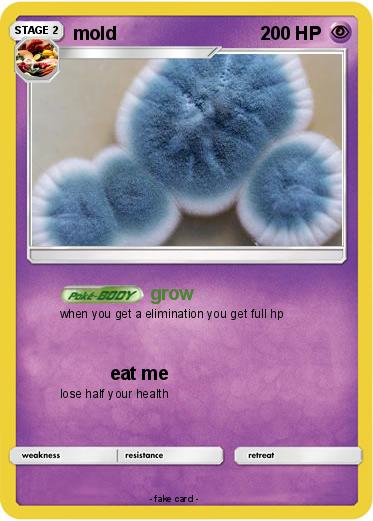
Pokemon mold

Pokemon mold 8
My card
Pokemon Passport
Creation Date : 15 December 2021
Name : mold
Type : Psychic
Attack 1 : grow
when you get a elimination you get full hp
Attack 2 : eat me
lose half your health
Related cards









MyPokeCard.com is a funny site to design your own pokemon card, vote for the best pokemon cards and create pokemon colorings